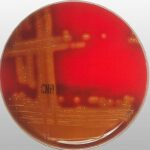
GELOSE AU SANG  (BOITE 60)  (sang de mouton)

GELOSE AU SANG (BOITE 60) (sang de mouton)
Réservé aux pros

GELOSE ANC (BASE)
Réservé aux pros
GELOSE AU SANG (BOITE 60) (sang de mouton)
Réservé aux pros

GELOSE ANC (BASE)
Réservé aux pros
GELOSE AU SANG + ANC (BOITE90) (sang de mouton)
Livraison sur toute la Tunisie
Produit certifié et de qualité
Livraison estimée: 17/04/2026 – 20/04/2026
UGS :
G0181
Catégorie : Milieux de cultures
💬
Besoin d’un devis ou d’un conseil ?
Vous avez besoin d’un devis, d’un conseil ou d’une commande en quantité ? Contactez notre équipe au +216 58 994 441 ou via WhatsApp.





